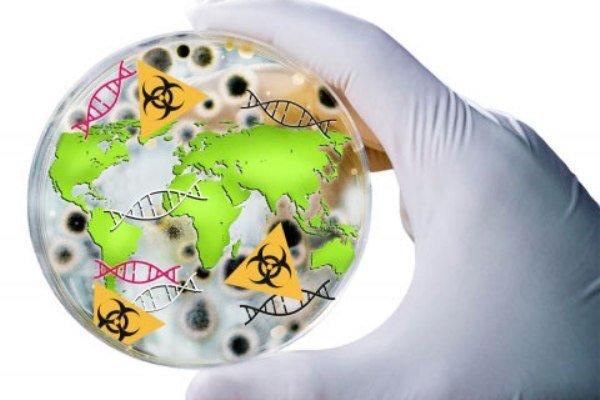
انتخاب اعضای ناظر در شورای ملی ایمنی زیستی

به گزارش خبرنگار نمایندگان ما، در جلسه علنی نوبت عصر امروز (دوشنبه ۷ شهریورماه) مجلس شورای اسلامی علیرضا عباسی با ۱۸۹ رأی و همایون سامه یح نجف آبادی با ۱۸۹ رأی به عنوان اعضای ناظر در شورای ملی ایمنی زیستی انتخاب شدند.
انتهای پیام
نمایندگان مجلس اعضای ناظر شورای ملی ایمنی زیستی را مشخص کردند.
به گزارش خبرنگار نمایندگان ما، در جلسه علنی نوبت عصر امروز (دوشنبه ۷ شهریورماه) مجلس شورای اسلامی علیرضا عباسی با ۱۸۹ رأی و همایون سامه یح نجف آبادی با ۱۸۹ رأی به عنوان اعضای ناظر در شورای ملی ایمنی زیستی انتخاب شدند.
انتهای پیام
نظر شما